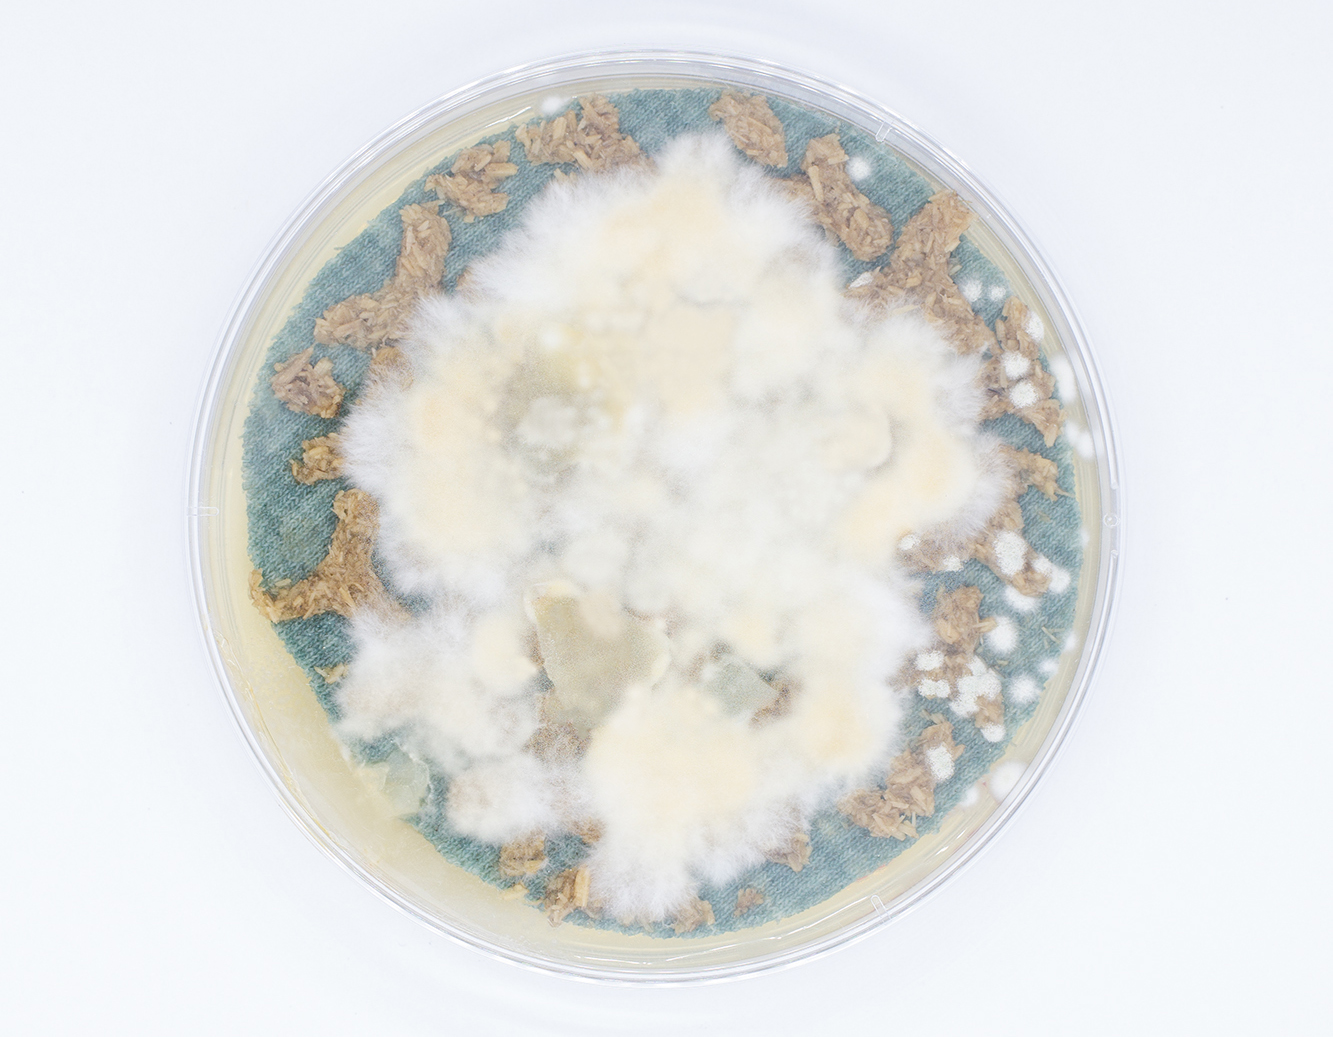

Im Kosmos der Mikroorganismen haben viele erstaunliche Eigenschaften. Hier haben wir uns auf ihre Wachstumsfähigkeit konzentriert. Wir wollten an diesem Prozess teilhaben, indem wir die Gestalt, Form oder sogar Eigenschaften dieser winzigen Lebewesen kontrollieren. Wir haben uns gefragt: Wie können wir Wachstum kreativ nutzen? Wie können Menschen und Organismen zusammenarbeiten, um neue Prozesse, Produkte oder Dienstleistungen zu schaffen? Und welche Rolle spielt der Organismus im Designprozess? Ist er ein Material, ein Designer oder etwas ganz anderes? Wir haben mit dem vom BioLab entwickelten Freeze-Slip-Gussverfahren experimentiert, um einen definierten Lebensraum und das Wachstum von Mikroorganismen zu schaffen. Um sich von der Zweidimensionalität der üblichen Petrischale im Labor zu befreien, ist es dem BioLab gelungen, ein Verfahren zu entwickeln, das das Potenzial hat, ideale Lebensräume für Mikroorganismen in drei Dimensionen zu schaffen. Das verwendete Material besteht hauptsächlich aus dem Hydrogel Alginat. Dieses wird in flüssigem Zustand in eine Negativform aus Silikon gegossen, tiefgefroren und anschließend in ein Bad aus Calciumchlorid getaucht. Das Alginat polymerisiert und behält auch nach dem Auftauen seine Form. Basierend auf dem Herstellungsverfahren des Schlickergusses hat das BioLab dieses Verfahren weiterentwickelt, um einen Lebensraum als Hohlkörper herzustellen. In dem Hohlraum können verschiedene Organismen gleichzeitig und vor allem formstabil wachsen.
Die Aufgabe bestand darin, die Möglichkeiten des dreidimensionalen Wachstums anhand spezifischer Anwendungskonzepte zu untersuchen. Welche Organismen lassen sich kombinieren, um welche Eigenschaften zu erzielen? Welche Materialien können in die Lebensräume eingebracht werden, damit sie von den Organismen aufgenommen oder verarbeitet werden? In welchen Kontexten sind gezüchtete Produkte wünschenswert?